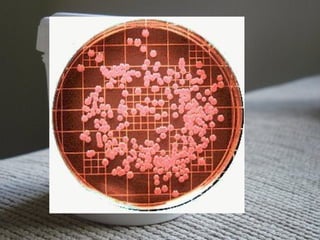

Urocultura e coprocultura são exames que analisam a urina e fezes para identificar bactérias causadoras de infecções. A coleta da urina deve ser feita corretamente, preferencialmente da primeira urina da manhã, e transportada em até 1 hora refrigerada. A coleta de fezes deve ser de pelo menos 2 gramas e transportada em até 24 horas refrigerada com conservante. Os meios de cultura identificam bactérias como Escherichia coli, Salmonella sp. e Campylobacter spp.